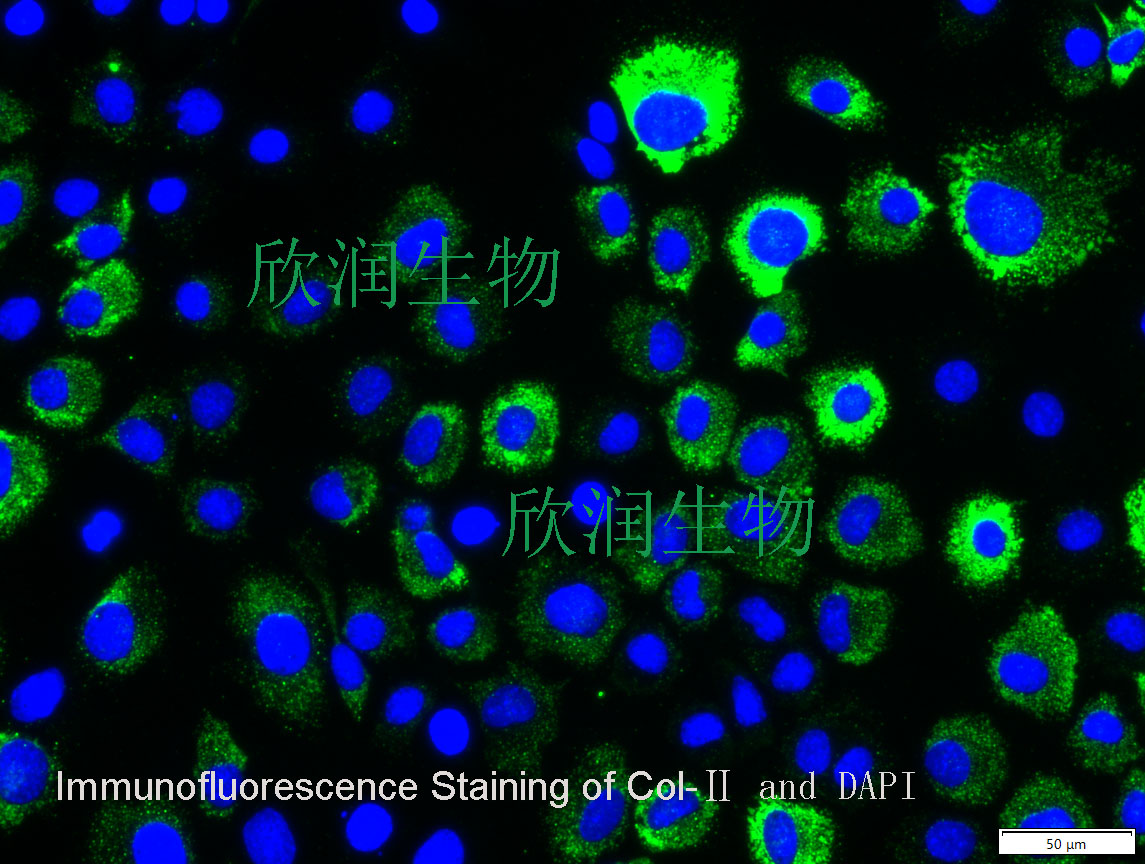
小鼠软骨细胞系、小鼠软骨成纤维细胞系、永生化小鼠软骨细胞、永

相关产品推荐更多 >
万千商家帮你免费找货
0 人在求购买到急需产品
- 详细信息
- 文献和实验
- 技术资料
- 英文名:
A
- 库存:
10
- 供应商:
欣润生物
- 肿瘤类型:
NO
- 细胞类型:
永生化
- ATCC Number:
11222
- 品系:
ICR小鼠
- 组织来源:
软骨组织
- 相关疾病:
无
- 物种来源:
小鼠
- 免疫类型:
不详
- 细胞形态:
上皮型
- 是否是肿瘤细胞:
否
- 器官来源:
软骨
- 运输方式:
常温
- 年限:
5年
- 生长状态:
贴壁生长
- 规格:
T25方瓶
永生化小鼠软骨细胞简介:
产品描述:软骨细胞(Chondrocyte),幼稚的软骨细胞位于软骨组织的表层,单个分布,体积较小,呈椭圆形,长轴与软骨表面平行,越向深层的软骨细胞体积之间增大呈圆形,细胞核圆形或卵圆形,染色浅,细胞质弱嗜碱性,常见数量不一的脂滴。软骨细胞具有合成和分泌基质与纤维的功能。
产品货号:IM2029
产品类型: 永生化细胞
传代能力: 30代左右
产品形态:上皮型
培养基:永生化小鼠软骨细胞完全培养基
支原体:呈阴性
产品培养条件:37℃,5%CO2
发货方式:T25瓶子常温发货
货期:1周左右货期
Col-II抗体免疫荧光染色鉴定
Reversibly Immortalized Mouse Articular Chondrocytes Acquire Long-Term Proliferative Capability while Retaining Chondrogenic Phenotype
Cartilage tissue engineering holds great promise for treating cartilaginous pathologies including degenerative disorders and traumatic injuries. Effective cartilage regeneration requires an optimal combination of biomaterial scaffolds, chondrogenic seed cells and biofactors. Obtaining sufficient chondrocytes remains a major challenge due to the limited proliferative capability of primary chondrocytes. Here, we investigate if reversibly immortalized mouse articular chondrocytes (iMACs) acquire long-term proliferative capability while retaining the chondrogenic phenotype. Primary mouse articular chondrocytes (MACs) can be efficiently immortalized with a retroviral vector expressing SV40 large T antigen flanked with Cre/loxP sites. iMACs exhibit long-term proliferation in culture, although the immortalization phenotype can be reversed by Cre recombinase. iMACs express the chondrocyte markers Col2a1 and aggrecan and produce chondroid matrix in micromass culture. iMACs form subcutaneous cartilaginous masses in athymic mice. Histologic analysis and chondroid matrix staining demonstrate
风险提示:丁香通仅作为第三方平台,为商家信息发布提供平台空间。用户咨询产品时请注意保护个人信息及财产安全,合理判断,谨慎选购商品,商家和用户对交易行为负责。对于医疗器械类产品,请先查证核实企业经营资质和医疗器械产品注册证情况。
文献和实验Chicken intestinal epithelial cells were obtained from NEWGAINBIO company. Cells were cultured on 37℃, with 5% CO2, in the Ham’s F-12 Nutrient (DMEM/12) that contained the following supplementations: fetal bovine serum (5%), in-sulin (5 µg/mL), transferrin (5 µg/mL), selenium (5 ng/mL), epidermal growth factor (5 ng/mL) and penicillin-streptomycin (100–100 U/mL) for cell culturing (full DMEM/12). Experiments were performed with chicken intestinal epithelial cells and working solutions were prepared with plain DMEM/12 without supplementation. For the investigations, cells were seeded onto 96-well, 24-well or 6-well polystyrene cell culture plates.
Primary hVICs (passage 2) were cultured to 50–60% confluence and infected with pGMLV-SV40T-puro lentivirus (NewgainBio, Wuxi, China) at a multiplicity of infection of 80 supplemented with 5 µg/mL polybrene (Sigma-Aldrich, Buchs, Switzerland).
Tissue was cultured until cells became visible around the tissue, and when the fusion reached 90% (FIGURE 1A) §ask ¦lled with the prepared culturing medium was sent to the company for further immortalisation. Cell immortalisation was done for cell stability and longer-term use. Immortalised cells were cultured with 10% FBS and 1% PS in the DMEM medium. After the cells multiplied and merged, they were routinely passed and grown ( NEWGAINBIO Inc. Wuxi, Jiangsu, China) (FIGURE 1B-C).
Mouse primary cultured renal vascular ECs and VSMCs were obtained from Newgainbio company, which were tested by Factor VIII and α-smooth muscle actin (α-SMA), the marker of ECs and VSMCs. RNeasy Mini Kit was used for RNA extraction, and the above protocols were repeated.
Porcine primary colon epithelial cells (Newgainbio company, Wuxi,China) were cultured in Dulbecco's Modified Eagle's Medium (Solarbio, Beijing, China) containing 10 % fetal bovine serum (BioInd, Kiryat shmona, Lsrael) at 37 ◦C and 5 % CO2 humidity.
-1细胞转化呢?原因是该细胞并非正常,而是已经永生化了的细胞,如果先用化学诱癌物或射线使正常大鼠原代成纤维细胞永生化,然后再用EJ-ras转染,则可使之转化,因此Weingerg按转染细胞表型的变化将癌基因分为两个类,一类是核内作用的能使细胞永生化的癌基因,例如myc,fos等,另一类是引起细胞恶性表型变化的定位于质膜和胞浆的癌基因,例如ras、erbB、src等。事实表明肿瘤的发生是多步骤,多因素的,不同的癌基因作用于肿瘤发生的不同阶段。 不仅癌基因之间有协同作用,癌基因与抑癌基因之间也存在
癌细胞有一系列不同于正常细胞的特性,如分化程度减弱,细胞形态和功能异常,自主性生长,浸润转移性和免疫性异常,体外培养无接触抑制和在软琼脂中形成集落的特性,癌细胞体外培养是研究癌变机理和癌细胞行为的极好方法,能为肿瘤病因学、遗传学和药理学等提供便利的条件。同时也是研究癌细胞的药物敏感性和诱导分化发生恶性逆转的最理想的对象。一、肿瘤病因和发病机制的研究癌细胞在体内恶性变时,易于形成肿瘤,但到体外培养时往往又难以培养成功,这不仅仅是因成纤维细胞的抑制作用,更重要的是体外缺乏有利于生长的微环
培养基:用含10%胎牛血清的DMEM培养液配制G418,G418浓度为200~800mg/L注意:对受体细胞先做预试验,选用浓度为在10~14天内能杀死细胞50%以上的最低浓度。2、操作步骤:(1)供体DNA制备:方法按前介绍的DNA提取法提取,溶于TE中,40mg/L。(2)受体细胞的培养:研究癌基因转移应选择不含人类Alu序列的动物细胞系作为受体细胞。如小鼠NIH3T3胚成纤维细胞系等,该细胞有一定自发转化倾向,一般在转染前一天接种细胞,接种密度为2×104/cm2,用含10%胎牛血清的DMEM液
技术资料






